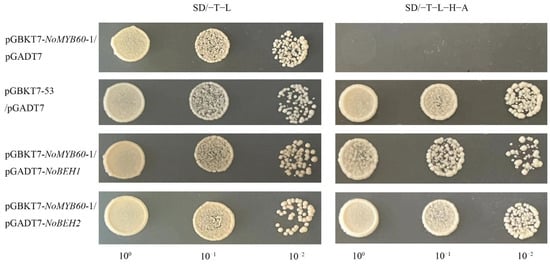

Abstract
The MYB60 gene belongs to the R2R3-MYB subfamily, which includes the MYB31/30/96/94 genes. Although these genes have been shown to respond to heat and drought stresses, their role in flavonoid synthesis remains unclear. In this study, NoMYB60 was cloned from watercress and its structure and function were analyzed. Sequence structure analysis showed that NoMYB60 had a highly conserved R2R3 DNA-binding region at the N-terminus. Under the treatment of ABA, SA or MeJA, the expression level of NoMYB60 first significantly increased and then decreased, indicating that ABA, SA and MeJA positively regulated NoMYB60. The subcellular localization of NoMYB60-GFP indicated that NoMYB60 was localized in the nuclear region, which is consistent with the molecular characterization of the transcription factor. Gene silencing experiments were also performed to further test the function of NoMYB60. The result showed that virus-induced silencing of NoMYB60 affected the expression of enzyme genes in flavonoid synthesis pathways and promoted the synthesis of flavonoids. Moreover, we discovered that NoMYB60 interacts with NoBEH1/2. In this study, provides a reference for research on the regulation mechanism of flavonoid synthesis in Cruciferae and other crops.
1. Introduction
Watercress (Nasturtium officinale R. BR.) is a cruciferous plant that is cultivated in many regions of China and also distributed in Asia, Europe and North America. The edible parts are the tender stems and leaves of the plant [1]. Flavonoids, a kind of polyphenols, which are found in almost all leaves, flowers, fruits and roots, are important for plant growth and stress resistance. Flavonoids are a vast class of secondary metabolites encompassing more than 10,000 structures [2], many of which are present in high amounts in vegetables and fruits. Structural genes and regulatory genes encoding major enzymes in flavonoid biosynthesis pathways have been identified in many crops [3,4]. The structural genes include phenylalanine ammonia-lyase (PAL), 4-coumarate:CoA ligase (4CL), cinnamate 4-hydroxylase (C4H), chalcone synthase (CHS), flavanone 3-hydroxylase (F3H), chalcone isomerase (CHI), flavonoid 3′-hydroxylase (F3′H), flavonol synthase (FLS), anthocyanin synthetase (ANS), dihydroflavonol 4-reductase (DFR), aUDP-glucose:flavonoid 3-O-glucosyltransferase (UFGT), etc. [5].
MYB-class transcription factors, referred to a class of transcription factors containing the MYB domain, play a key role in regulating flavonoid biosynthesis and stress tolerance. As a member of the R2R3-MYB family in Arabidopsis thaliana, MYB60 is characterized by a reduced defense-cell-specific expression pattern under drought stress [6]. In addition, overexpression of MYB44, another protective-cell-specific member of the MYB family, is associated with enhanced ABA sensitivity and faster stomatal closure compared with wild-type plants, resulting in reduced expression of the gene-encoding type 2C protein phosphatase (a known negative regulator) [7]. This partly explains the enhanced tolerance of MYB44-overexpressing plants to abiotic stress. MYB61 is another MYB superfamily member, also belonging to the R2R3-MYB family, and is involved in the response leading to stomatal closure [8]. Seo et al. found that MYB96-mediated ABA signaling can be integrated into the auxin signaling pathway [9]. ABA induced the expression of MYB96 but inhibits the expression of MYB60. These results indicate that the expression of each gene in the MYB family is delicately controlled, with specificity.
MYB60 genes can improve the tolerance of seedlings to high salt stress [10]. For example, overexpression of cotton GbMYB60 in Arabidopsis increased salt sensitivity of transgenic Arabidopsis [11]. Lv Y et al. identified and expressed the MYB gene family of Koelreuteria bipinnata Franch and predicted that the KbMYB60 gene negatively regulates anthocyanin synthesis [12]. In this study, the MYB60 gene was identified from watercress, named NoMYB60, which has a highly conserved R2R3 domain and is expressed in the nucleus. Under exogenous ABA, SA or MeJA treatment, the transcription level of NoMYB60 first gradually increased and then decreased. In order to further test the function of NoMYB60, gene silencing experiments were carried out. After NoMYB60 gene silencing, the key genes of the flavonoid synthesis pathway were upregulated or downregulated to varying degrees. The interaction between NoMYB60 and NoBEH1/2 was confirmed by yeast two-hybrid and bimolecular fluorescence complementation techniques. These results indicated that NoMYB60 is involved in the biosynthesis of flavonoids in watercress.
2. Materials and Methods
2.1. Plant Material
Plants of the watercress cultivar used in this study were provided by the Chinese Cabbage System Biology Laboratory of Nanjing Agricultural University. The material was imported from the US, where it had been bred by Seed Needs Company “https://www.myseedneeds.com/ (accessed on 3 November 2018)”. All plants were grown in a climatic chamber at 24 °C/18 °C with a 16 h/8 h light/dark cycle.
Before the hormone treatment, watercress seedings of length about 15 cm were cut and cultivated in the Hoagland nutrient solution. The watercress root was immersed in approximately 2 cm of nutrient solution. After 15 days, the plants were divided into three groups: SA group, ABA group and MeJA group. Volumes of 5 mg/L SA, 5 mg/L ABA and 1 mg/L MeJA were used for hydroponic treatment, respectively. Leaf samples were collected after 0 h, 2 h, 4 h, 6 h, 12 h, 24 h, 36 h and 48 h. All collected samples were placed in the refrigerator at −80 °C for use.
For the virus-induced gene silencing (VIGS) assay, watercress with a length of about 15 cm was cut and cultured in nutrient solution. After 15 days, NoMYB60-silenced plants were obtained using gene gun-mediated transformation (1300 psi, PDS-1000/He, Bio-Rad, Hercules, CA, USA).
2.2. Sequence Analysis
The PlantCARE website “http://bioinformatics.psb.ugent.be/webtools/plantcare/html/ (accessed on 5 August 2020)” was used to analyze the cis-acting elements of the promoter, and the result is shown in Table 1. The ExPASy website “https://web.expasy.org/protparam/ (accessed on 10 August 2020)” was used to analyze the physical and chemical properties of NoMYB60 protein; DNAMAN software to analyze the amino acid multi sequence alignment; and the MEME website to analyze the amino acid sequence conservative motif. The phylogenetic tree was constructed using MEGA 7.0 by the neighbor-joining method with 1000 bootstrap replicates.

Table 1.
Information on NoMYB60 promoters.
2.3. Quantitative Real-Time PCR Analysis
The total RNA of the plant samples was isolated using the RNA Simple Total RNA Kit (TIANGEN, Beijing, China). The RNA purity and concentration were determined using a Micro-Spectrophotometer (ALLsheng, Hangzhou, China). The integrity of RNA was verified by performing 1.2% agarose gel electrophoresis. An amount of 1 μg of total RNA was used for cDNA synthesis with HiScript III RT SuperMix for qPCR (+gDNA wiper) (Vazyme, Nanjing, China). The full-length cDNA sequences of PAL, C4H, 4CL, CHs, F3H, DFR, ANS, UFGT and NoMYB60 were isolated by 5′ and 3′ RACE with PrimeSTAR® Max DNA Polymerase (Takara, Beijing, China). RT-qPCR experiments were performed on an Applied Biosystems StepOnePlusTM Real-Time PCR System Thermal Cycling Block using Hieff UNICON® qPCR SYBR Green Master Mix (Yeasen, Shanghai, China). The reactions were performed in a 20 µL total volume containing 10 µL of Hieff UNICON® qPCR SYBR Green Master Mix, 1.0 µL of diluted cDNA, 0.4 µL of each primer and 7.2 µL ddH2O. The following amplification program was used: 95 °C for 30 s, followed by 40 cycles of 95 °C for 10 s, 60 °C for 20 s and 72 °C for 20 s in 96-well quantitative PCR plate (Mulinsen, Nanjing, China). To analyze the melting curve for determine primer specificity, we added a procedure of 95 °C for 15 s and 60 °C for 1 min, followed by 95 °C for 15 s. Specific primers (Table S1) for qRT-PCR analysis were designed with Primer3Plus “https://www.primer3plus.com/index.html (accessed on 25 August 2020)”.
2.4. Determination of Total Flavonoid Content
The sample was dried to a constant weight, pulverized, and passed through a 40-mesh sieve, weighed about 0.02 g. 2 mL of extract was added and shaken at 60 °C for 2 h and then centrifuged at 10,000 rpm, rest at 25 °C for 10 min. Finally, the supernatant was collected for further analysis (Suzhou Comin Biotechnology Co., Ltd., Suzhou, China).
2.5. Virus-Induced Gene Silencing (VIGS)-Mediated Silencing of NoMYB60 in Watercress
A specific 40 bp fragment was selected from the coding region of NoMYB60, combined with its antisense sequence to synthesize and insert into a PTY-S (PTY) vector. PTY is a carrier of the TYMV-VIGS system. The synthesis of fragments and the construction of silencing vectors were performed by the GeneScript company (Nanjing, China). The hairpin structural sequence of VIGS is listed in Table S2. Watercress of length about 15 cm was used in this VIGS test. The 4 µg PTY and NoMYB60-PTY plasmids were wrapped in gold particles, and then four watercress plants were bombarded using the gene-gun-mediated transformation (1300 psi, PDS-1000/He, Bio-Rad, Hercules, CA, USA). Two weeks later, the leaves showing virus-mottled leaf surfaces were sampled for detection.
2.6. Transcriptional Activation Activity Assays
The transcriptional activation activity of NoMYB60 was studied using a yeast two-hybrid (Y2H) system. The full-length cDNA of NoMYB60 was fused to the 3′ end of the GAL4 DNA binding domain of the PGBKT7(BD) vector to obtain the BD-NoMYB60 construct. The BD-NoMYB60 construct was co-transformed with the empty pGADT7 vector (AD) into the yeast strain Y2H gold.
Subsequently, according to the functional domain of the NoMYB60 protein sequence, the sequence was divided into two segments at the 227th amino acid and constructed into the BD vector. BD-NoMYB60 (full-length sequence) and BD-NoMYB60-1 (1–227, amino acids) were obtained and stored at −20 °C for later use. See Table S1 for specific primers for constructing the BD vector. Identify transcriptional activation domains (TADs) as described above.
2.7. Yeast Two-Hybrid (Y2H) Assays
The recombinant plasmid BD-NoMYB60-1 was co-transferco-transferred into yeast competent cells with AD-NoBEH1 and AD-NoBEH2, respectively, plotted on SD/-Trp/-Leu medium and cultured for 2–3 days. A single colony was selected and transferred to YPDA liquid medium for overnight culture. The cloning primers of the gene were used for PCR detection. The OD of bacterial solution was adjusted to 0.8–1.0, and 8 μL bacterial solution was cultured on SD/-Leu/-Trp and SD/-Ade/-His/-Leu/-Trp medium at 28 °C for 3–4 days. Then the cell growth was observed. The same operation was performed on the control.
2.8. Bimolecular Fluorescence Complementary (BiFC) Assays
The coding sequence of NoMYB60 was amplified with primers YC-NoMYB60-F and YC-NoMYB60-R (Table S1) and cloned into the pUC-SPYCE vector to generate NoMYB60-cYFP plasmids. The coding sequence of NoBEH1/2 was amplified by primers YN-NoBEH1/2-F and YN-NoBEH1/2-R (Table S1) and cloned into pUC-SPYNE to generate NoBEH1-nYFP and NoBEH2-nYFP. The plasmid mixtures (NoMYB60-cYFP and NoBEH1-nYFP, NoMYB60-cYFP and NoBEH1-nYFP, NoMYB60-cYFP, nYFP) were introduced into tobacco cells. After 24–48 h incubation, the cells were observed and photographed with a laser confocal microscope.
3. Results
3.1. Identification of NoMYB60 and Sequence Alignment
The cDNA sequence of NoMYB60 was isolated from watercress, encoding a protein of 281 amino acids with a predicted molecular mass of 32.01 kDA and theoretical pI of 5.79. It is an unstable hydrophobic protein. Amino acid multiple sequence alignment of MYB60 proteins of different species, including Arabidopsis (At), pak choi (Brassica campestris (syn. Brassica rapa) ssp. Chinensis; Bc), N. officinale (No), Oryza sativa (Os), Zea mays (Zm), Solanum lycopersicum (Sl), Daucus carota (Dc) and Triticum aestivum (Ta), showed that the N-terminal of the MYB60 protein has a highly conserved R2R3 domain and two unique conserved regions, Box1 and Box2 (Figure 1A).

Figure 1.
Multiple sequence alignment and structure analysis of MYB60 protein. (A) Multiple sequence alignment of MYB60 protein in different species, including Arabidopsis (At), pak choi (Bc), N. officinale (No), O. sativa (Os), Z. mays (Zm), S. lycopersicum (Sl), D. carota (Dc) and T. aestivum (Ta). The conserved R2R3 domain sequence is marked above the purple line and the conserved Box1 and Box2 sequences are marked in the green box. (B) MYB60 protein has a conservative motif distribution, and the related sequence information of ten motifs is at the bottom of the picture.
Furthermore, the results from multiple sequence alignment showed that the NoMYB60 protein shares 48.92%, 42.57%, 42.68% and 48.92% identity with OsMYB306-1, ZmMYB306, TaMYB60-like and DcMYB306, respectively, while it shares 86.62% and 80.43% identity with AtMYB60 in Arabidopsis and BcMYB60 in pak choi, which further confirmed the conservation of cruciferous plants in the evolutionary process. The NCBI accession numbers of genes are shown in Table S3.
Motif distribution studies showed that motif 1, motif 2, motif 4 of N-terminal and motif 3 and motif 5 of C-terminal were highly conserved among all MYB60 proteins (Figure 1B). In addition, PSIPRED 4.0 was used to predict the secondary structure. It was found that the NoMYB60 protein is mainly composed of α-helix (98 amino acids, 35%) and irregular curl (182 amino acids, 65%).
3.2. Phylogenetic Analysis of MYB60
In order to analyze the phylogenetic relationship of MYB60 protein among species, an unrooted neighbor-joining (NJ) phylogenetic tree was constructed with MEGA 7.0 software, including S. lycopersicum, O. sativa, Z. mays, D. carota, Arabidopsis, D. carota, pak choi and N. officinale. In the phylogenetic tree MYB60 proteins of different species are divided into two larger groups SlMYB306 and ZmMYB306. The shared position in a single branch indicates that the two genes are genetically close though they belong to different species (Figure 2). Furthermore, the results of evolutionary analysis show that AtMYB60 of Arabidopsis, NoMYB60 of N. officinale, BcMYB60 of pak choi, SlMYB306-like of S. lycopersicum and DcMYB306 and DcMYB306-like of D. carota are closely related. They are relatively conserved in the evolution process and may originate from the same ancestral gene. In addition, compared with other species, NoMYB60 of N. officinale is more closely related to AtMYB60 of Arabidopsis.

Figure 2.
Phylogenetic analysis of MYB60 genes in different species. The phylogenetic tree of MYB60 was constructed by MEGA7.0, including Arabidopsis (At), pak choi (Bc), N. officinale (No), O. sativa (Os), Z. mays (Zm), S. lycopersicum (Sl), D. carota (Dc) and T. aestivum (Ta).
3.3. Expression Pattern Analysis of NoMYB60
MYB transcription factors are widely involved in plant secondary metabolism. In order to explore the role of the NoMYB60 gene in flavonoid synthesis of watercress, samples from different watercress tissues were taken to analyze the expression pattern of NoMYB60 gene, as shown in Figure 3A. The expression of NoMYB60 was different in different tissues, and the expression of NoMYB60 was higher in the petiole, the leaf and especially the root. Furthermore, by analyzing the promoter of the NoMYB60 gene through the PlantCARE website, we found that the promoter sequence of NoMYB60 includes one cis-acting element (ABRE) in response to ABA, one cis-acting element (CGTCA) in response to MeJA and two cis-acting elements (TCA elements) in response to SA. Previous studies have shown that ABRE cis-acting elements play an important role in mediating the regulation of ABA [13,14], CGTCA cis-acting elements play an important role in mediating the regulation of MeJA [15] and TCA cis-acting elements play an important role in mediating the regulation of SA [16]. Therefore, we conclude that the NoMYB60 gene may respond to ABA, SA and MeJA. As shown in Figure 3B–D, our study of the expression profile of the NoMYB60 gene in watercress under ABA, SA and MeJA treatments using qRT-PCR showed that NoMYB60 has a trend of increasing first and then decreasing after ABA, MeJA and SA treatments. The expression of NoMYB60 was the highest at 12 h after ABA treatment, the expression of NoMYB60 was the highest at 36 h after MeJA treatment and the expression of NoMYB60 was the highest at 2 h after SA treatment. These results are also consistent with the fact that MYB60 is a transcription factor regulated by ABA, SA and MeJA (Figure 3).

Figure 3.
Expression profile of NoMYB60 gene in watercress. (A) NoMYB60 expression levels in different tissues (root, stem, petiole and leaf). The error lines represent the standard errors, different letters represent significant differences, p < 0.05. (B–D) expression analysis of NoMYB60 under respect ABA, SA and MeJA treatments. Watercress, cut to a length of about 15 cm, was exposed to ABA (5 mg/L), SA (5 mg/L) and MeJA (1 mg/L) treatments over a consecutive time course (0, 2, 4, 6, 8, 12, 24, 36 and 48 h). The horizontal axis represents processing times and the vertical axis represents the relative expression.
3.4. Subcellular Localization of NoMYB60 Protein
35S:GFP and 35S:NoMYB60-GFP fusion expression vectors were constructed (Figure 4A), and transformed into tobacco. After 48–72 h of Agrobacterium injection, the localization of NoMYB60 protein was observed and photographed with a confocal laser scanning microscope. The results show that 35S:NoMYB60-GFP fusion protein emits green fluorescence in the nucleus, indicating that NoMYB60 is located in the nucleus (Figure 4).

Figure 4.
Subcellular localization of NoMYB60. (A) The construct of 35S:NoMYB60-GFP fusion protein; (B) localization of 35S:NoMYB60-GFP in tobacco leaves was observed under a laser confocal microscope. The panels from left to right show mCherry (nuclear marker), bright field, fluorescence and merged fluorescence images.
3.5. Virus-Induced NoMYB60 Silencing Caused Increased Flavonoid Content in Watercress
To further verify the effect of NoMYB60 on the flavonoid synthesis of watercress, virus-induced gene silencing (VIGS) was used to obtain loss-of-function plants. The phenotype of mosaic leaves is emblematic of a silencing plant, and this became increasingly apparent in the positive plants of NoMYB60-PTY and PTY after two weeks. The potential loss-of-function plants were collected, and the silencing efficiency of NoMYB60 was evaluated by qRT-PCR. As shown in Figure 5, the transcript abundance of NoMYB60 decreased by more than 80% in NoMYB60-silenced plants #1, #3 and #7 in comparison with the PTY plant. The flavonoid content of NoMYB60-PTY and PTY plants was determined, and the flavonoid content after gene silencing was found to have increased to varying degrees (Figure 5C). This result reveals the function of NoMYB60 in flavonoid synthesis.

Figure 5.
Virus-induced NoMYB60 silencing in watercress. (A) Relative expression of NoMYB60 in silent plants. Error bars represent standard errors. (B) Plant phenotype after silencing of NoMYB60 gene. (C) Flavonoid content in silenced plants (**, p < 0.05).
3.6. Effect of Virus-Induced NoMYB60 Silencing on Key Genes of Flavonoid Synthesis Pathway
In order to determine whether or not the NoMYB60 gene is involved in the regulation of the flavonoid synthesis pathway in watercress, molecular detection was performed on the expression of key genes in the flavonoid synthesis pathway in NoMYB60 transgenic watercress (Figure 6). Compared with PTY plant, the transcription levels of PAL, C4H and 4CL genes in the earlier stage of the flavonoid synthesis pathway in NoMYB60-PTY plants were down-regulated to varying degrees, and the expression of CHs, F3H, DFR, ANS and UFGT genes in the late stage of the flavonoid synthesis pathway were up-regulated to varying degrees, indicating that NoMYB60 regulates flavonoid synthesis by mediating key genes of the flavonoid synthesis pathway.

Figure 6.
Effects of NoMYB60 silencing in watercress on transcription levels of genes related to flavonoid metabolism in watercress. (A) PAL: phenylalanine ammonia-lyase; (B) C4H: cinnamic acid 4-hydroxylase; (C) 4CL: 4-coumarate:CoA ligase; (D) CHs: Chalcone synthase; (E) F3H: flavanone 3-hydroxylase; (F) DFR: dihydroflavonol-4-reductase; (G) ANS: anthocyanin synthase; (H) UFGT: UDP-glucose:flavonoid 3- O-glucosyltransferase; ** represent p < 0.05.
3.7. NoMYB60 Interacts with NoBEH1/2 In Vitro
In apples, MYB60 interacts with BEH [17]. In order to verify whether or not MYB60 and BEH interact in watercress, we cloned homologous genes NoBEH1 and NoBEH2, and we verified the interaction relationship by Y2H. We first performed the transcription activation assay of the NoMYB60 gene (Figure 7) and found that yeast cells transferred to pGBKT7-NoMYB60 and pGADT7 can grow normally in SD/−T/−L and SD/−T−L−H−A media, indicating that NoMYB60 has transcriptional activation activity. According to the structural characteristics of the NoMYB60 protein sequence, it was truncated and retained its N-terminal and intermediate regions (1–277 amino acids), then called NoMYB60-1. The results showed that the yeast transformant of pGBKT7-NoMYB60-1 plasmid could not grow on the SD/−T−L−H−A medium, indicating that NoMYB60-1 has no self-activation, and the transcriptional activation region of NoMYB60 was at the C-terminal.

Figure 7.
Transcriptional activation activity analysis of NoMYB60. Transcription activity assay of NoMYB60 in yeast. NoMYB60 and NoMYB60-1 represent the full-length protein, as well as the regions encoding 1–277 amino acids of NoMYB60, respectively, which were inserted into the pGBKT7 vector.
In the Y2H assay, we discovered that co-transformation containing the PGADT7-NoBEH1/2 and pGBKT7-NoMYB60-1 plasmids could grow on both SD/−T−L and SD/−T−L−H−A media. This result indicates that NoMYB60 may physically interact with NoBEH1/2 (Figure 8).
Figure 8.
Yeast two-hybrid analysis of interaction between NoMYB60 and NoBEH1/2. The verification of the interaction between NoMYB60-1 and NoBEH1/2 by Y2H assay. The yeast cells were grown on the SD media: SD/−T−L (left), SD/−T−L−H−A (right). pGBKT7-53/pGADT7 were used as the positive control. 100, 10−1 and 10−2 represent the concentrations of yeast solutions.
3.8. Verification of the Interaction between NoMYB60 and NoBEH1/2 by BiFC
The binding relationship between NoMYB60 and potential interacting proteins was further analyzed by BiFC assay. No yellow fluorescence signal was found in tobacco leaf epidermal cells co-transformed with NoMYB60-cYFP and empty vector nYFP, while significant YFP yellow fluorescence signal was found in tobacco leaf epidermal cells co-transformed with NoBEH1/2-nYFP and NoMYB60-cYFP, indicating that NoMYB60 interacts with NoBEH1/2 in the nucleus of tobacco cells (Figure 9).

Figure 9.
BiFC analysis of the interaction between NoMYB60 and NoBEH1/2 in tobacco leaves. The yellow fluorescence signal is displayed in a dark field, bright field and merged, respectively. Scale bar, 100 µm.
4. Discussion
Flavonoids are important substances for plants to resist free radicals and antioxidants, and they play a crucial role in the nutritional quality of plants. Therefore, analyzing the biosynthesis of flavonoids is of great significance to germplasm optimization and production practice. In this study, we isolated and cloned a flavonoid biosynthesis-related gene from watercress and named it the NoMYB60 gene due to its high homology with Arabidopsis AtMYB60.
Many studies have shown that the MYB60 gene is an important promoter in the hormone signal transduction pathway [11,18] and plays an important role in various biological processes, such as promoting root growth and regulating stomatal activity [6,19]. This study found that NoMYB60 was highly expressed in roots (Figure 3A), which may be related to the gene’s involvement in stomatal regulation as it plays a role in promoting root growth and increasing water absorption. The expression of NoMYB60 in watercress treated with ABA, SA and MeJA first increased and then decreased, which proved that NoMYB60 could respond to ABA, SA and MeJA treatment.
The synthesis of flavonoids is affected not only by structural genes, but also by regulatory factors, their own growth and development signals, and the external environment. Many researchers have proved that MYB transcription factors, especially R2R3-MYB transcription factors, play an important role in the flavonoid metabolic pathway. In Eutrema salsugineum, overexpression of the EsMYB90 gene can induce the expression of key flavonoid synthesis enzyme genes such as PAL and CHs, resulting in the accumulation of anthocyanins [20].In grape, overexpression of the VvMYBPA1 gene can specifically induce the expression of LAR and ANR [21], resulting in increased accumulation of tannins. In this study, with the NoMYB60 gene silenced, the transcription levels of NoPAL, NoC4H and No4CL in the early stage of the flavonoid synthesis pathway were downregulated to varying degrees, and the expression levels of NoCHs, NoF3H, NoDFR, NoANS and NoUFGT genes in the later stage of the flavonoid synthesis pathway were upregulated to varying degrees. A similar situation also appeared in Vitis davidii. When the VdMYB14 gene was overexpressed, the expression of the key genes affecting anthocyanin synthesis, NtLAR and NtANR, was significantly increased, while the expression of the key gene in the anthocyanin synthesis pathway, NtUFGT, was significantly downregulated [22]. Similar to the above-mentioned plant MYB transcription factor, NoMYB60 has different transcriptional regulation effects on each enzyme gene of the flavonoid biosynthesis pathway.
The MYB60 gene has different biological functions in different plants. For example, overexpression of the AtMYB60 gene in Lactuca sativa results in leaf decolorization [23]. However, in Arabidopsis, V. vinifera and S. lycopersicum, and loss-of-function mutation of AtMYB60 causes stomatal closure, thereby increasing resistance to drought, but without any phenotypic effect [6,24,25]. In order to elucidate the biological function of the NoMYB60 transcription factor in watercress, we first demonstrated that NoMYB60 is a transcription factor localized in the nucleus by subcellular localization (Figure 4). To further analyze the regulatory role of NoMYB60 in the flavonoid metabolic pathway, we constructed a NoMYB60-PTY silencing vector using VIGS technology and transformed watercress using the gene gun method (Figure 5). Through RT-qPCR detection (Figure 6), it was found that after the virus-induced silencing of NoMYB60, the expression levels of upstream key enzyme genes NoPAL, NoC4H and No4CL in the flavonoid metabolic pathway were downregulated, and the expression levels of the downstream enzyme genes NoCHs, NoF3H, NoDFR, NoANS and NoUFGT were upregulated, resulting in increased accumulation of flavonoids. Therefore, we speculate that NoMYB60 negatively regulates flavonoid biosynthesis by inhibiting the expression of key genes such as NoCHs. In addition, the transcriptional activation activity assay of NoMYB60 indicated that NoMYB60 is a transcriptional activator. Meanwhile, this study verified the interaction between NoMYB60 and NoBEH1/2 by Y2H and BiFC. Studies have shown that the BZR family transcription factor BEH is involved in BR-regulated flavonoid biosynthesis [17]. Therefore, we speculate that NoMYB60 may participate in BR signal transduction by interacting with NoBEH1/2, thereby regulating the biosynthesis of flavonoids in watercress. However, the specific synthesis mechanism of the NoMYB60 gene in flavonoid synthesis in watercress remains to be further studied.
5. Conclusions
The full-length coding sequence of the NoMYB60 gene was cloned from watercress, and its structure and function were analyzed. NoMYB60 has a high expression level in the roots, leaves and petioles in response to ABA, SA and MeJA. Virus-induced gene silencing assays demonstrated that NoMYB60 participates in the biosynthesis of flavonoids. Furthermore, the Y2H and BiFC assays showed that NoMYB60 proteins display transcriptional activation activity and interact with NoBEH1/2. These findings contributed to our further understanding of MYB60 in cruciferous plants and provided a solid foundation for further research on the regulatory mechanism of flavonoid synthesis in Nasturtium or other species.
Supplementary Materials
The following supporting information can be downloaded at: https://www.mdpi.com/article/10.3390/genes13112109/s1, Table S1 Primers used for cloning and vector construction; Table S2 Sequences of oligonucleotides used for VIGS; Table S3 Accession number of genes in NCBI.
Author Contributions
Conceptualization, X.H., X.M., J.R. and X.Y.; formal analysis, X.M.; investigation, X.M. and G.M.; writing—original draft preparation, X.M.; writing—review and editing, X.M., G.M. and J.R. All authors have read and agreed to the published version of the manuscript.
Funding
This work was partially supported by the Key Projects of the National Key Research and Development Plan (2017YFD0101803), the State Key Program of the Natural Science Foundation of China (31330067), the China Agriculture Research System (CARS-23-A-06), the National Natural Science Foundation of China (no. 11171155, no. 11871268), and the Natural Science Foundation of Jiangsu Province, China (no. SBK2019043238, BK20171370).
Institutional Review Board Statement
Not applicable.
Informed Consent Statement
Not applicable.
Data Availability Statement
Data are available on request.
Conflicts of Interest
The authors declare no conflict of interest.
References
- Gounden, D.; Kisten, K.; Moodley, R.; Shaik, S.; Jonnalagadda, S.B. Impact of Spiked Concentrations of Cd, Pb, As and Zn in Growth Medium on Elemental Uptake of Nasturtium officinale (Watercress). J. Environ. Sci. Health B 2016, 51, 1–7. [Google Scholar] [CrossRef] [PubMed]
- Brunetti, C.; Di Ferdinando, M.; Fini, A.; Pollastri, S.; Tattini, M. Flavonoids as Antioxidants and Developmental Regulators: Relative Significance in Plants and Humans. Int. J. Mol. Sci. 2013, 14, 3540–3555. [Google Scholar] [CrossRef] [PubMed]
- Winkel-Shirley, B. Biosynthesis of Flavonoids and Effects of Stress. Curr. Opin. Plant Biol. 2002, 5, 218–223. [Google Scholar] [CrossRef]
- Koes, R.; Verweij, W.; Quattrocchio, F. Flavonoids: A Colorful Model for the Regulation and Evolution of Biochemical Pathways. Trends Plant Sci. 2005, 10, 236–242. [Google Scholar] [CrossRef] [PubMed]
- Shen, N.; Wang, T.F.; Gan, Q.; Liu, S.; Wang, L.; Jin, B. Plant Flavonoids: Classification, Distribution, Biosynthesis, and Antioxidant Activity. Food Chem. 2022, 383, 132531. [Google Scholar] [CrossRef] [PubMed]
- Cominelli, E.; Galbiati, M.; Vavasseur, A.; Conti, L.; Sala, T.; Vuylsteke, M.; Leonhardt, N.; Dellaporta, S.L.; Tonelli, C. A Guard-Cell-Specific MYB Transcription Factor Regulates Stomatal Movements and Plant Drought Tolerance. Curr. Biol. 2005, 15, 1196–1200. [Google Scholar] [CrossRef]
- Jung, C.; Jun, S.S.; Sang, W.H.; Yeon, J.K.; Chung, H.K.; Sang, I.S.; Baek, H.N.; Yang, D.C.; Cheong, J.J. Overexpression of AtMYB44 Enhances Stomatal Closure to Confer Abiotic Stress Tolerance in Transgenic Arabidopsis. Plant Physiol. 2008, 146, 623–635. [Google Scholar] [CrossRef]
- Liang, Y.K.; Dubos, C.; Dodd, I.C.; Holroyd, G.H.; Hetherington, A.M.; Campbell, M.M. AtMYB61, an R2R3-MYB Transcription Factor Controlling Stomatal Aperture in Arabidopsis Thaliana. Curr. Biol. 2005, 15, 1201–1206. [Google Scholar] [CrossRef]
- Seo, P.J.; Xiang, F.; Qiao, M.; Park, J.Y.; Lee, Y.N.; Kim, S.G.; Lee, Y.H.; Park, W.J.; Park, C.M. The MYB96 Transcription Factor Mediates Abscisic Acid Signaling during Drought Stress Response in Arabidopsis. Plant Physiol. 2009, 151, 275–289. [Google Scholar] [CrossRef]
- Gao, W.; Liu, H.L.; Tian, X.Q.; Zhang, H.; Song, J.; Yang, Y.; Long, L.; Song, C.P. Cloning, Expression, and Functional Analysis of Transcription Factor Gene GbMYB60 in Cotton. Acta Agron. Sin. 2016, 42, 1342–1351. [Google Scholar] [CrossRef]
- Xu, F.C.; Liu, H.L.; Xu, Y.Y.; Zhao, J.R.; Guo, Y.W.; Long, L.; Gao, W.; Song, C.P. Heterogeneous Expression of the Cotton R2R3-MYB Transcription Factor GbMYB60 Increases Salt Sensitivity in Transgenic Arabidopsis. Plant Cell Tissue Organ Cult. 2018, 133, 15–25. [Google Scholar] [CrossRef]
- Lv, Y.Z.; Dong, X.Y.; Liang, Z.H.; Sun, H.N.; Huang, L.B.; Jiang, Z.P. Transcriptome-wide Identification and Expression Profiling of the MYB Gene Family in Koelreuteria bipinnata var. integrifoliola. J. Northeast For. Univ. 2021, 49, 33–38. [Google Scholar] [CrossRef]
- Fujita, Y.; Fujita, A.M.; Satoh, C.R.; Maruyama, C.K.; Parvez, A.; Seki, A.M. AREB1 Is a Transcription Activator of Novel ABRE-Dependent ABA Signaling That Enhances Drought Stress Tolerance in Arabidopsis. Plant Cell 2005, 17, 3470–3488. [Google Scholar] [CrossRef] [PubMed]
- Yoshida, T.; Fujita, Y.; Sayama, H.; Kidokoro, S.; Maruyama, K.; Mizoi, J.; Shinozaki, K.; Yamaguchi-shinozaki, K. AREB1, AREB2, and ABF3 Are Master Transcription Factors That Cooperatively Regulate ABRE-Dependent ABA Signaling Involved in Drought Stress Tolerance and Require ABA for Full Activation. Plant J. 2010, 61, 672–685. [Google Scholar] [CrossRef]
- Yan, J.; Wang, B.; Jiang, Y.; Cheng, L.; Wu, T. GmFNSII-Controlled Soybean Flavone Metabolism Responds to Abiotic Stresses and Regulates Plant Salt Tolerance. Plant Cell Physiol. 2014, 55, 74–86. [Google Scholar] [CrossRef]
- Wang, Y.; Liu, G.J.; Yan, X.F.; Wei, Z.G.; Xu, Z.R. MeJA-Inducible Expression of the Heterologous JAZ2 Promoter from Arabidopsis in Populus Trichocarpa Protoplasts. J. Plant Dis. Prot. 2011, 118, 69–74. [Google Scholar] [CrossRef]
- Wang, Y.; Mao, Z.; Jiang, H.; Zhang, Z.; Wang, N.; Chen, X. Brassinolide Inhibits Flavonoid Biosynthesis and Red-Flesh Coloration via the MdBEH2.2-MdMYB60 Complex in Apple. J. Exp. Bot. 2021, 72, 6382–6399. [Google Scholar] [CrossRef]
- Rusconi, F.; Simeoni, F.; Francia, P.; Cominelli, E.; Conti, L.; Riboni, M.; Simoni, L.; Martin, C.R.; Tonelli, C.; Galbiati, M. The Arabidopsis Thaliana MYB60 Promoter Provides a Tool for the Spatio-Temporal Control of Gene Expression in Stomatal Guard Cells. J. Exp. Bot. 2013, 64, 3361–3371. [Google Scholar] [CrossRef]
- Cominelli, E.; Galbiati, M.; Albertini, A.; Fornara, F.; Conti, L.; Coupland, G.; Tonelli, C. DOF-Binding Sites Additively Contribute to Guard Cell-Specificity of AtMYB60 Promoter. BMC Plant Biol. 2011, 11, 162–174. [Google Scholar] [CrossRef]
- Qi, Y.; Gu, C.; Wang, X.; Gao, S.; Li, C.; Zhao, C.; Li, C.; Ma, C.; Zhang, Q. Identification of the Eutrema Salsugineum EsMYB90 Gene Important for Anthocyanin Biosynthesis. BMC Plant Biol. 2020, 20, 186. [Google Scholar] [CrossRef]
- Bogs, J.; Jaffé, F.W.; Takos, A.M.; Walker, A.R.; Robinson, S.P. The Grapevine Transcription Factor VvMYBPA1 Regulates Proanthocyanidin Synthesis during Fruit Development. Plant Physiol. 2007, 143, 1347–1361. [Google Scholar] [CrossRef] [PubMed]
- Li, S.C.; Sun, L.; Fan, X.C.; Zhang, Y.; Jiang, J.F.; Liu, C.H. Analysis of the Function of the R2R3-MYB Transcription Factor VdMYB14 in Grapevine in Regulating Flavonoid Synthesis. J. Fruit Sci. 2020, 37, 783–792. [Google Scholar] [CrossRef]
- Park, J.S.; Kim, J.B.; Cho, K.J.; Cheon, C.I.; Sung, M.K.; Choung, M.G.; Roh, K.H. Arabidopsis R2R3-MYB Transcription Factor AtMYB60 Functions as a Transcriptional Repressor of Anthocyanin Biosynthesis in Lettuce (Lactuca Sativa). Plant Cell Rep. 2008, 27, 985–994. [Google Scholar] [CrossRef] [PubMed]
- Galbiati, M.; Matus, J.T.; Francia, P.; Rusconi, F.; Cañón, P.; Medina, C.; Conti, L.; Cominelli, E.; Tonelli, C.; Arce-Johnson, P. The Grapevine Guard Cell-Related VvMYB60 Transcription Factor Is Involved in the Regulation of Stomatal Activity and Is Differentially Expressed in Response to ABA and Osmotic Stress. BMC Plant Biol. 2011, 11, 142–155. [Google Scholar] [CrossRef]
- Rodríguez-Hoces de la Guardia, A.; Ugalde, M.B.; Lobos-Diaz, V.; Romero-Romero, J.L.; Meyer-Regueiro, C.; Inostroza-Blancheteau, C.; Reyes-Diaz, M.; Aquea, F.; Arce-Johnson, P. Isolation and Molecular Characterization of MYB60 in Solanum Lycopersicum. Mol. Biol. Rep. 2021, 48, 1579–1587. [Google Scholar] [CrossRef]
Publisher’s Note: MDPI stays neutral with regard to jurisdictional claims in published maps and institutional affiliations. |
© 2022 by the authors. Licensee MDPI, Basel, Switzerland. This article is an open access article distributed under the terms and conditions of the Creative Commons Attribution (CC BY) license (https://creativecommons.org/licenses/by/4.0/).